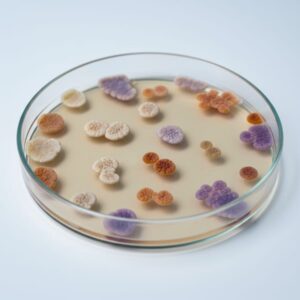

⏱️ 6 min read
Evolution has equipped animals with remarkable survival mechanisms that often seem more fitting for science fiction than reality. From creatures that can survive in the vacuum of space to animals that essentially live forever, the natural world is filled with adaptations that challenge our understanding of biological possibility. These evolutionary innovations demonstrate nature's incredible creativity in solving survival challenges across millions of years.
Extraordinary Evolutionary Innovations
1. The Pistol Shrimp's Sonic Weapon
The pistol shrimp possesses one of nature's most devastating weapons despite measuring only a few centimeters long. This small crustacean has evolved an oversized claw that can snap shut with such speed that it creates a cavitation bubble. When this bubble collapses, it produces a shockwave reaching speeds of 60 miles per hour and temperatures nearly as hot as the sun's surface—approximately 4,700 degrees Celsius. The resulting sonic boom stuns or kills prey instantly. This adaptation is so powerful that colonies of pistol shrimp can actually interfere with submarine sonar communications.
2. Tardigrades' Extreme Survival Mechanism
Tardigrades, also known as water bears, have evolved perhaps the most extreme survival adaptation in the animal kingdom. These microscopic creatures can enter a state called cryptobiosis, essentially shutting down their metabolism to nearly zero. In this state, they can survive temperatures ranging from near absolute zero to 150 degrees Celsius, withstand pressure six times greater than the deepest ocean trenches, endure radiation levels hundreds of times higher than would kill humans, and even survive the vacuum of space. They achieve this by producing unique proteins that form a glass-like matrix, protecting their cells from damage.
3. The Axolotl's Regenerative Powers
The Mexican axolotl has evolved regenerative capabilities that far exceed any other vertebrate. Unlike most amphibians that undergo metamorphosis, axolotls retain their juvenile features throughout life—a condition called neoteny. More remarkably, they can regenerate entire limbs, portions of their heart, spinal cord, and even parts of their brain without scarring. The regenerated body parts function perfectly and include complex structures like bones, muscles, and nerves. Scientists believe this ability stems from special cells called blastemal cells that can transform into any tissue type needed.
4. Electric Eels' Biological Battery System
Electric eels have evolved specialized organs called electrocytes that function as biological batteries. These modified muscle cells are stacked in series like batteries in a flashlight, allowing the eel to generate shocks up to 860 volts—enough to stun a horse. The eel can control the intensity and frequency of these discharges, using weak pulses for navigation and communication, and powerful jolts for hunting and defense. Approximately 80% of the eel's body is devoted to these electric organs, making it one of the most specialized predators in freshwater environments.
5. The Bombardier Beetle's Chemical Defense
The bombardier beetle has evolved one of nature's most sophisticated chemical weapons. It stores two relatively harmless chemicals—hydroquinone and hydrogen peroxide—in separate chambers within its abdomen. When threatened, the beetle mixes these chemicals in a special reaction chamber containing enzymes and water. The resulting chemical reaction occurs so rapidly that it produces a toxic, boiling spray at approximately 100 degrees Celsius. The beetle can aim this spray with remarkable accuracy using special movable nozzles, and can fire up to 20 pulses in rapid succession.
6. Immortal Jellyfish's Life Cycle Reversal
Turritopsis dohrnii, commonly called the immortal jellyfish, has evolved the ability to reverse its life cycle. When faced with physical damage, starvation, or environmental stress, this jellyfish can transform its adult cells back into polyp-stage cells through a process called transdifferentiation. Essentially, it reverts to its juvenile form and starts its life cycle over again. This adaptation theoretically allows the species to bypass death from old age entirely, making it biologically immortal. No other multicellular organism is known to possess this capability.
7. Archerfish Precision Water Jets
Archerfish have evolved the remarkable ability to hunt insects above the water's surface by shooting them down with precise jets of water. These fish can accurately compensate for light refraction at the water's surface, which makes prey appear in a different location than it actually occupies. They shoot water from their mouths by pressing their tongue against a groove in the roof of their mouth, creating a powerful jet that can reach heights of up to three meters. Young archerfish learn this skill through practice, demonstrating that this adaptation combines both evolutionary biology and learned behavior.
8. The Mimic Octopus's Shape-Shifting Abilities
The mimic octopus can impersonate over 15 different marine species, including lionfish, sea snakes, flatfish, and jellyfish. This adaptation goes far beyond simple camouflage—the octopus actively changes its body shape, swimming style, and behavior to match its chosen model. It achieves this through specialized skin cells called chromatophores that can change color instantly, combined with its boneless body that can contort into various shapes. The octopus appears to choose which animal to mimic based on which predator threatens it, suggesting sophisticated cognitive processing.
9. Wood Frogs' Freeze Tolerance
Wood frogs have evolved the ability to survive being frozen solid during winter. As temperatures drop, these frogs accumulate high concentrations of glucose in their vital organs, which acts as a cryoprotectant—essentially biological antifreeze. Their hearts stop beating, they stop breathing, and up to 70% of their body water turns to ice. Ice crystals form in compartments outside their cells rather than inside them, preventing cellular damage. When spring arrives, they thaw naturally and resume normal functions within hours, suffering no ill effects from their frozen state.
10. Platypus Electroreception System
The platypus has evolved the ability to detect electrical fields generated by muscle contractions in prey animals. Its bill contains approximately 40,000 electroreceptor cells that can detect electrical signals as weak as 50 microvolts. When hunting underwater with its eyes and ears closed, the platypus relies entirely on this electrolocation to find hidden prey like freshwater shrimp buried in stream beds. This adaptation is particularly remarkable because the platypus is a mammal, and electroreception is far more common in fish and sharks. The bill also contains mechanoreceptors that detect pressure changes, giving the platypus a complete sensory picture of its underwater environment.
Nature's Endless Innovation
These ten extraordinary adaptations represent just a fraction of the remarkable evolutionary solutions found throughout the animal kingdom. From chemical weapons and biological electricity to immortality and freeze tolerance, wildlife continues to demonstrate that reality can be stranger than fiction. Each adaptation reflects millions of years of evolutionary refinement, where species developed increasingly specialized tools to survive in their particular ecological niches. Understanding these mechanisms not only deepens our appreciation for biodiversity but also inspires technological innovations in fields ranging from medicine to materials science. As we continue studying these natural wonders, we undoubtedly will discover even more surprising ways that life has adapted to thrive in Earth's diverse environments.